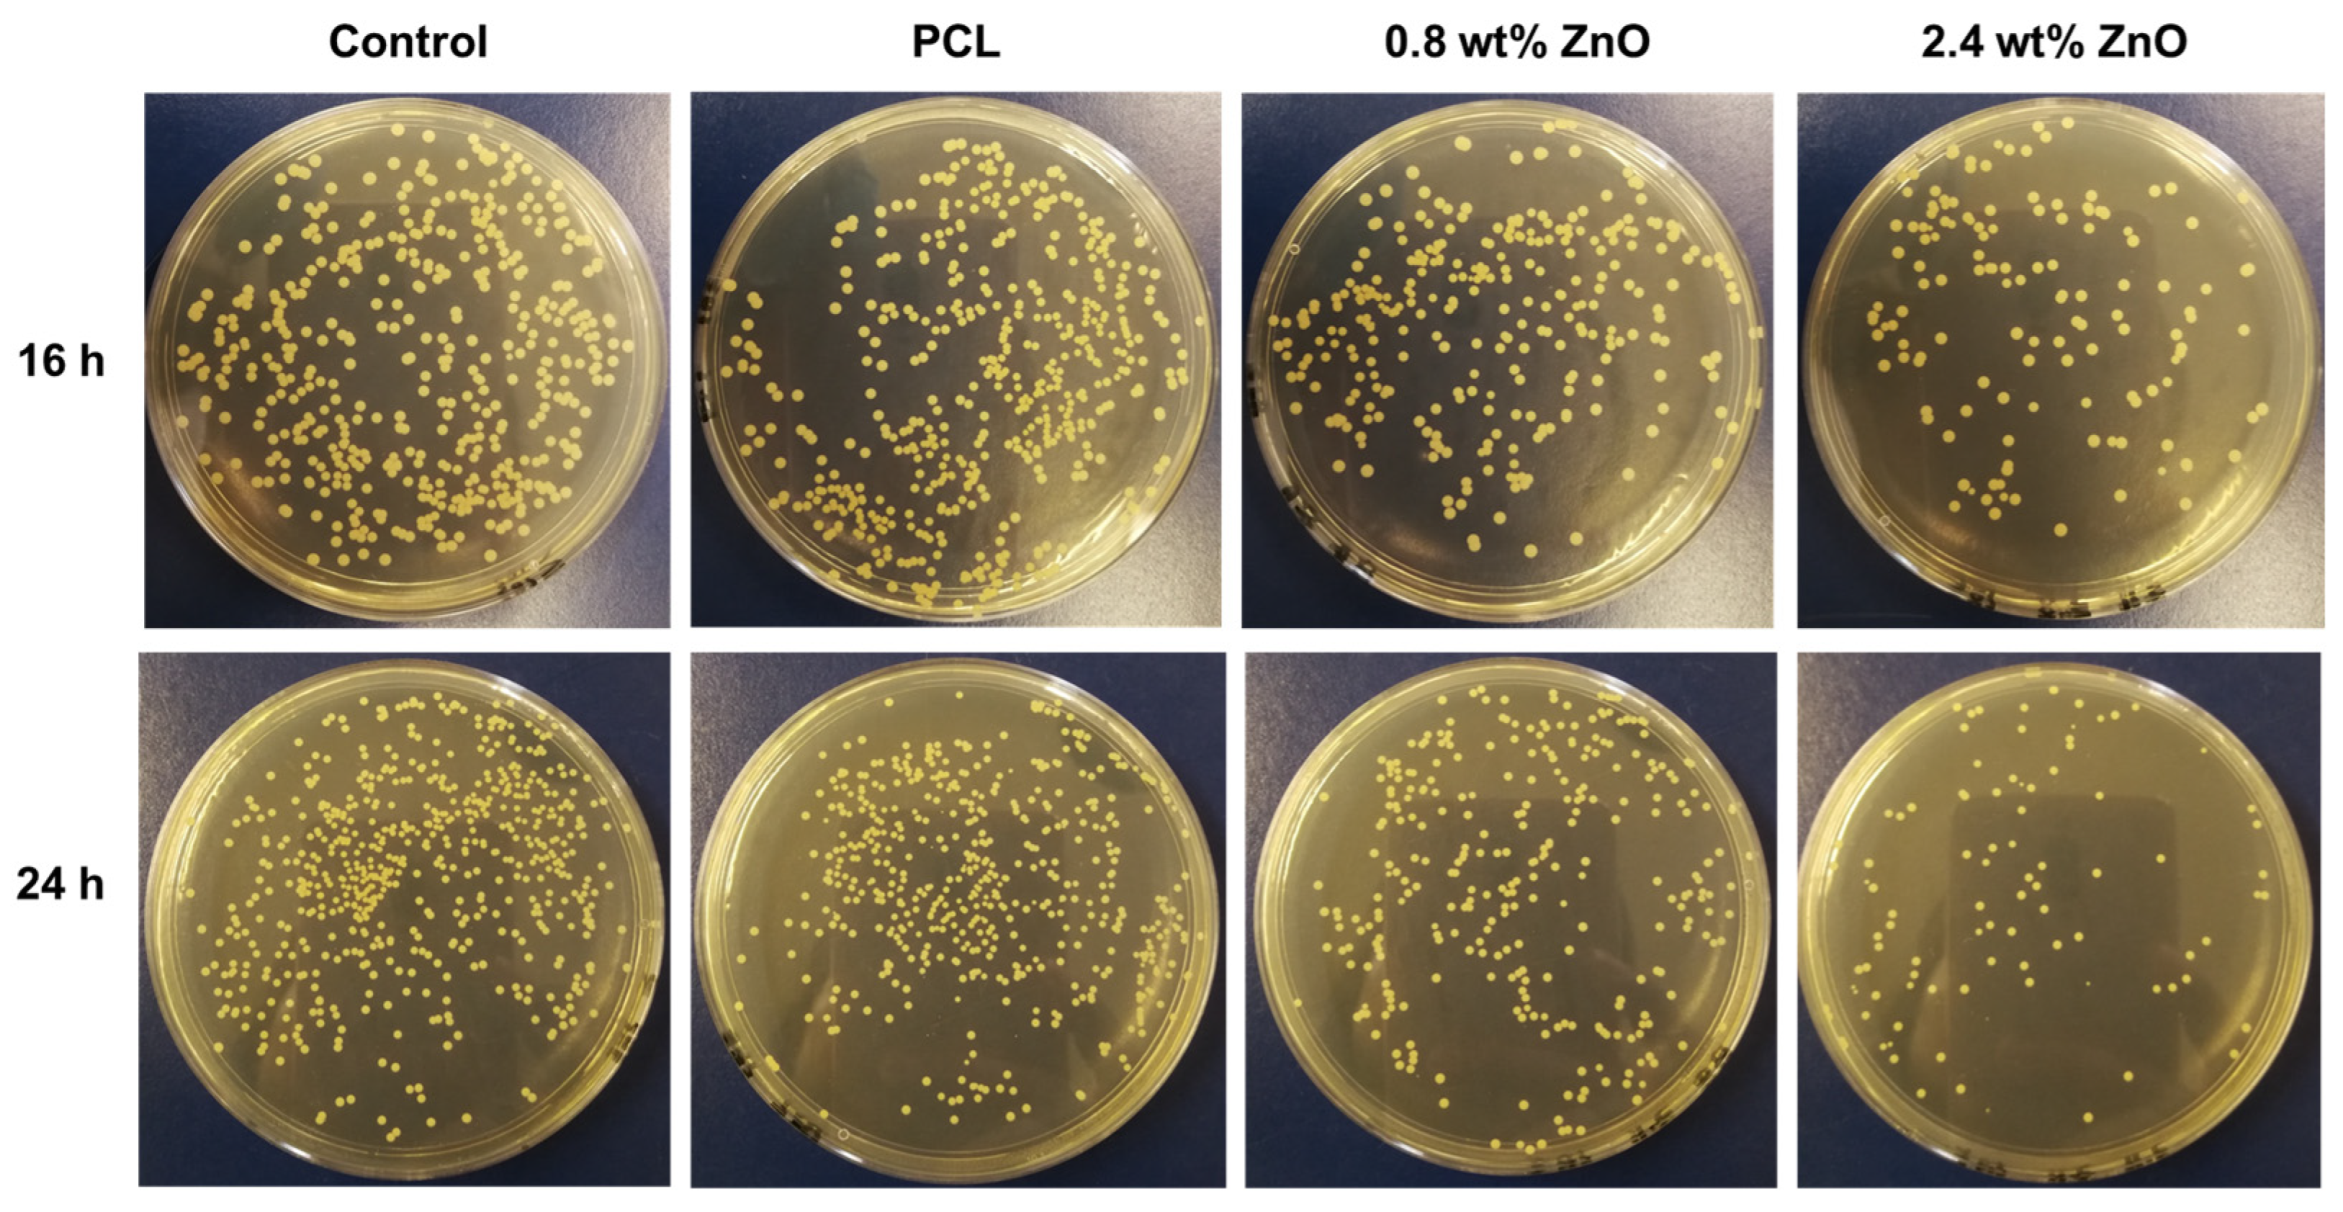
Ijms 24 14420 g006

Enhanced Antibacterial Ability of Electrospun PCL Scaffolds Incorporating ZnO Nanowires
Abstract
:1. Introduction
2. Results and Discussion
2.1. Preparation and Characterisation of PCL/ZnO Scaffolds
2.1.1. Fabrication and Characterisation of ZnO NWs
2.1.2. Electrospinning of PCL/ZnO Scaffolds
2.1.3. Characterisation of PCL/ZnO Scaffolds
2.2. Antimicrobial Ability of PCL/ZnO Scaffolds
2.2.1. The Dose of ZnO NWs on Antimicrobial Ability
2.2.2. The Effect of Disinfecting Time on Antimicrobial Ability
2.2.3. The Effect of Visible Light on Antimicrobial Ability
2.3. The Biocompatibility of PCL/ZnO Scaffolds
3. Materials and Methods
4. Conclusions
Author Contributions
Funding
Informed Consent Statement
Data Availability Statement
Acknowledgments
Conflicts of Interest
References
- Siddiqui, N.; Asawa, S.; Birru, B.; Baadhe, R.; Rao, S. PCL-Based Composite Scaffold Matrices for Tissue Engineering Applications. Mol. Biotechnol. 2018, 60, 506–532. [Google Scholar] [CrossRef] [PubMed]
- Qian, Y.; Zhou, X.; Zhang, F.; Diekwisch, T.G.; Luan, X.; Yang, J. Triple PLGA/PCL Scaffold Modification Including Silver Impregnation, Collagen Coating, and Electrospinning Significantly Improve Biocompatibility, Antimicrobial, and Osteogenic Properties for Orofacial Tissue Regeneration. ACS Appl. Mater. Interfaces 2019, 11, 37381–37396. [Google Scholar] [CrossRef] [PubMed]
- Zhang, W.; Yu, M.; Cao, Y.; Zhuang, Z.; Zhang, K.; Chen, D.; Liu, W.; Yin, J. An anti-bacterial porous shape memory self-adaptive stiffened polymer for alveolar bone regeneration after tooth extraction. Bioact. Mater. 2023, 21, 450–463. [Google Scholar] [CrossRef]
- Ahmed, M.K.; Zayed, M.A.; El-Dek, S.I.; Hady, M.A.; El Sherbiny, D.H.; Uskokovic, V. Nanofibrous epsilon-polycaprolactone scaffolds containing Ag-doped magnetite nanoparticles: Physicochemical characterization and biological testing for wound dressing applications in vitro and in vivo. Bioact. Mater. 2021, 6, 2070–2088. [Google Scholar] [CrossRef] [PubMed]
- Qin, H.; Cao, H.; Zhao, Y.; Jin, G.; Cheng, M.; Wang, J.; Jiang, Y.; An, Z.; Zhang, X.; Liu, X. Antimicrobial and osteogenic properties of silver-ion-implanted stainless steel. ACS Appl. Mater. Interfaces 2015, 7, 10785–10794. [Google Scholar] [CrossRef]
- Gunes Cimen, C.; Dundar, M.A.; Demirel Kars, M.; Avci, A. Enhancement of PCL/PLA Electrospun Nanocomposite Fibers Comprising Silver Nanoparticles Encapsulated with Thymus vulgaris L. Molecules for Antibacterial and Anticancer Activities. ACS Biomater. Sci. Eng. 2022, 8, 3717–3732. [Google Scholar] [CrossRef] [PubMed]
- Xu, L.; Wang, Y.Y.; Huang, J.; Chen, C.Y.; Wang, Z.X.; Xie, H. Silver nanoparticles: Synthesis, medical applications and biosafety. Theranostics 2020, 10, 8996–9031. [Google Scholar] [CrossRef]
- Ferrone, E.; Araneo, R.; Notargiacomo, A.; Pea, M.; Rinaldi, A. ZnO Nanostructures and Electrospun ZnO-Polymeric Hybrid Nanomaterials in Biomedical, Health, and Sustainability Applications. Nanomaterials 2019, 9, 1449. [Google Scholar] [CrossRef]
- Zhou, J.; Xu, N.S.; Wang, Z.L. Dissolving Behavior and Stability of ZnO Wires in Biofluids: A Study on Biodegradability and Biocompatibility of ZnO Nanostructures. Adv. Mater. 2006, 18, 2432–2435. [Google Scholar] [CrossRef]
- Khader, A.; Arinzeh, T.L. Biodegradable zinc oxide composite scaffolds promote osteochondral differentiation of mesenchymal stem cells. Biotechnol. Bioeng. 2020, 117, 194–209. [Google Scholar] [CrossRef]
- Colon, G.; Ward, B.C.; Webster, T.J. Increased osteoblast and decreased Staphylococcus epidermidis functions on nanophase ZnO and TiO2. J. Biomed. Mater. Res. A 2006, 78, 595–604. [Google Scholar] [CrossRef] [PubMed]
- Vannozzi, L.; Gouveia, P.; Pingue, P.; Canale, C.; Ricotti, L. Novel Ultrathin Films Based on a Blend of PEG-b-PCL and PLLA and Doped with ZnO Nanoparticles. ACS Appl. Mater. Interfaces 2020, 12, 21398–21410. [Google Scholar] [CrossRef] [PubMed]
- Beikzadeh, S.; Hosseini, S.M.; Mofid, V.; Ramezani, S.; Ghorbani, M.; Ehsani, A.; Mortazavian, A.M. Electrospun ethyl cellulose/poly caprolactone/gelatin nanofibers: The investigation of mechanical, antioxidant, and antifungal properties for food packaging. Int. J. Biol. Macromol. 2021, 191, 457–464. [Google Scholar] [CrossRef] [PubMed]
- Huang, K.; Jinzhong, Z.; Zhu, T.; Morsi, Y.; Aldalbahi, A.; El-Newehy, M.; Yan, X.; Mo, X. Exploration of the antibacterial and wound healing potential of a PLGA/silk fibroin based electrospun membrane loaded with zinc oxide nanoparticles. J. Mater. Chem. B 2021, 9, 1452–1465. [Google Scholar]
- Ke, D.; Bose, S. Doped tricalcium phosphate bone tissue engineering scaffolds using sucrose as template and microwave sintering: Enhancement of mechanical and biological properties. Mater. Sci. Eng. C Mater. Biol. Appl. 2017, 78, 398–404. [Google Scholar] [CrossRef]
- Maghfoori, F.; Najmoddin, N.; Pezeshki-Modaress, M. Enhancing mechanical and antibacterial properties of polycaprolactone nanocomposite nanofibers using decorated clay with ZnO nanorods. J. Appl. Polym. Sci. 2022, 139, e52684. [Google Scholar] [CrossRef]
- Hatamie, A.; Khan, A.; Golabi, M.; Turner, A.P.; Beni, V.; Mak, W.C.; Sadollahkhani, A.; Alnoor, H.; Zargar, B.; Bano, S.; et al. Zinc oxide nanostructure-modified textile and its application to biosensing, photocatalysis, and as antibacterial material. Langmuir 2015, 31, 10913–10921. [Google Scholar] [CrossRef]
- Tian, J.J.; Feng, H.Q.; Yan, L.; Yu, M.; Ouyang, H.; Li, H.; Jiang, W.; Jin, Y.M.; Zhu, G.; Li, Z.; et al. A self-powered sterilization system with both instant and sustainable antibacterial ability. Nano Energy 2017, 36, 241–249. [Google Scholar] [CrossRef]
- Li, Z.; Tang, H.; Yuan, W.; Song, W.; Niu, Y.; Yan, L.; Yu, M.; Dai, M.; Feng, S.; Wang, M.; et al. Ag nanoparticle-ZnO nanowire hybrid nanostructures as enhanced and robust antimicrobial textiles via a green chemical approach. Nanotechnology 2014, 25, 145702. [Google Scholar] [CrossRef]
- Phadke, A.; Hwang, Y.; Kim, S.H.; Kim, S.H.; Yamaguchi, T.; Masuda, K.; Varghese, S. Effect of scaffold microarchitecture on osteogenic differentiation of human mesenchymal stem cells. Eur. Cells Mater. 2013, 25, 114–129. [Google Scholar] [CrossRef]
- Ferreira, F.V.; Otoni, C.G.; Lopes, J.H.; de Souza, L.P.; Mei, L.H.; Lona, L.M.; Lozano, K.; Lobo, A.O.; Mattoso, L.H. Ultrathin polymer fibers hybridized with bioactive ceramics: A review on fundamental pathways of electrospinning towards bone regeneration. Mater. Sci. Eng. C Mater. Biol. Appl. 2021, 123, 111853. [Google Scholar] [CrossRef] [PubMed]
- Liu, M.; Liu, Y.; Zhou, L. Novel Flexible PVDF-TrFE and PVDF-TrFE/ZnO Pressure Sensor: Fabrication, Characterization and Investigation. Micromachines 2021, 12, 602. [Google Scholar] [CrossRef]
- Rivero, P.J.; Fuertes, J.P.; Vicente, A.; Mata, Á.; Palacio, J.F.; Monteserín, M.; Rodríguez, R. Modeling Experimental Parameters for the Fabrication of Multifunctional Surfaces Composed of Electrospun PCL/ZnO-NPs Nanofibers. Polymers 2021, 13, 4312. [Google Scholar] [CrossRef] [PubMed]
- Zhou, F.; Cui, C.; Sun, S.; Wu, S.; Chen, S.; Ma, J.; Li, C.M. Electrospun ZnO-loaded chitosan/PCL bilayer membranes with spatially designed structure for accelerated wound healing. Carbohydr. Polym. 2022, 282, 119131. [Google Scholar] [CrossRef] [PubMed]
- Rahmani, A.; Hashemi-Najafabadi, S.; Eslaminejad, M.B.; Bagheri, F.; Sayahpour, F.A. The effect of modified electrospun PCL-nHA-nZnO scaffolds on osteogenesis and angiogenesis. J. Biomed. Mater. Res. A 2019, 107, 2040–2052. [Google Scholar] [CrossRef]
- Pang, C.; Mackevica, A.; Tian, J.; Feng, H.; Li, Z.; Baun, A. Release of Ag/ZnO Nanomaterials and Associated Risks of a Novel Water Sterilization Technology. Water 2019, 11, 2276. [Google Scholar] [CrossRef]
- Blachowicz, T.; Ehrmann, A. Recent developments in electrospun ZnO nanofibers: A short review. J. Eng. Fibers Fabr. 2020, 15, 1–6. [Google Scholar] [CrossRef]
- Preda, M.D.; Popa, M.L.; Neacsu, I.A.; Grumezescu, A.M.; Ginghina, O. Antimicrobial Clothing Based on Electrospun Fibers with ZnO Nanoparticles. Int. J. Mol. Sci. 2023, 24, 1629. [Google Scholar] [CrossRef]
- Mahmoodabadi, A.N.; Kompany, A.; Mashreghi, M. Characterization, antibacterial and cytotoxicity studies of graphene-Fe3O4 nanocomposites and Fe3O4 nanoparticles synthesized by a facile solvothermal method. Mater. Chem. Phys. 2018, 213, 285–294. [Google Scholar] [CrossRef]
- Banitaba, S.N.; Semnani, D.; Heydari-Soureshjani, E.; Rezaei, B.; Ensafi, A.A. Effect of titanium dioxide and zinc oxide fillers on morphology, electrochemical and mechanical properties of the PEO-based nanofibers, applicable as an electrolyte for lithium-ion batteries. Mater. Res. Express 2019, 6, 0850d6. [Google Scholar] [CrossRef]
- Kayaci, F.; Ozgit-Akgun, C.; Biyikli, N.; Uyar, T. Surface-decorated ZnO nanoparticles and ZnO nanocoating on electrospun polymeric nanofibers by atomic layer deposition for flexible photocatalytic nanofibrous membranes. RSC Adv. 2013, 3, 6817–6820. [Google Scholar] [CrossRef]
- Patil, P.P.; Meshram, J.V.; Bohara, R.A.; Nanaware, S.G.; Pawar, S.H. ZnO nanoparticle-embedded silk fibroin–polyvinyl alcohol composite film: A potential dressing material for infected wounds. New J. Chem. 2018, 42, 14620–14629. [Google Scholar] [CrossRef]
- Raghupathi, K.R.; Koodali, R.T.; Manna, A.C. Size-dependent bacterial growth inhibition and mechanism of antibacterial activity of zinc oxide nanoparticles. Langmuir 2011, 27, 4020–4028. [Google Scholar] [CrossRef] [PubMed]
- Stanić, V.; Dimitrijević, S.; Antić-Stanković, J.; Mitrić, M.; Jokić, B.; Plećaš, I.B.; Raičević, S. Synthesis, characterization and antimicrobial activity of copper and zinc-doped hydroxyapatite nanopowders. Appl. Surf. Sci. 2010, 256, 6083–6089. [Google Scholar] [CrossRef]
- Yang, T.; Wang, D.; Liu, X. Antibacterial activity of an NIR-induced Zn ion release film. J. Mater. Chem. B 2020, 8, 406–415. [Google Scholar] [CrossRef] [PubMed]
- Li, Y.; Xie, S.; Xu, D.; Shu, G.; Wang, X. Antibacterial activity of ZnO quantum dots and its protective effects of chicks infected withSalmonella pullorum. Nanotechnology 2021, 32, 505104. [Google Scholar] [CrossRef]
- Jones, N.; Ray, B.; Ranjit, K.T.; Manna, A.C. Antibacterial activity of ZnO nanoparticle suspensions on a broad spectrum of microorganisms. FEMS Microbiol. Lett. 2008, 279, 71–76. [Google Scholar] [CrossRef]
- Rao, B.N.; Rao, P.T.; Vasudha, K.; Basha, S.E.; Prasanna, D.S.; Rao, T.B.; Samatha, K.; Ramachandra, R.K. Physiochemical characterization of sodium doped zinc oxide nano powder for antimicrobial applications. Spectrochim. Acta A Mol. Biomol. Spectrosc. 2023, 291, 122297. [Google Scholar]
- Do Truc, V.; Vuong Nguyen, T.; Viet Vu, T.; Anh Nguyen, T.; Dung Ngo, T.; Tam Le, T.; Lu Le, T.; Thi Pham, L.; Dai Tran, L. ZnO−Ag Hybrid Nanoparticles Used in the Antimicrobial Solvent-Based Coatings: Antibacterial Studies in the Darkness and Under Visible-Light Irradiation. ChemistrySelect 2023, 8, e202204966. [Google Scholar] [CrossRef]
- Nguyen, V.T.; Vu, V.T.; Nguyen, T.H.; Nguyen, T.A.; Tran, V.K.; Nguyen-Tri, P. Antibacterial Activity of TiO2- and ZnO-Decorated with Silver Nanoparticles. J. Compos. Sci. 2019, 3, 61. [Google Scholar] [CrossRef]
- Dethe, M.R.; Prabakaran, A.; Ahmed, H.; Agrawal, M.; Roy, U.; Alexander, A. PCL-PEG copolymer based injectable thermosensitive hydrogels. J. Control. Release 2022, 343, 217–236. [Google Scholar] [CrossRef] [PubMed]
- Paterson, T.E.; Shi, R.; Tian, J.; Harrison, C.J.; De Sousa Mendes, M.; Hatton, P.V.; Li, Z.; Ortega, I. Electrospun Scaffolds Containing Silver-Doped Hydroxyapatite with Antimicrobial Properties for Applications in Orthopedic and Dental Bone Surgery. J. Funct. Biomater. 2020, 11, 58. [Google Scholar] [CrossRef] [PubMed]

Disclaimer/Publisher’s Note: The statements, opinions and data contained in all publications are solely those of the individual author(s) and contributor(s) and not of MDPI and/or the editor(s). MDPI and/or the editor(s) disclaim responsibility for any injury to people or property resulting from any ideas, methods, instructions or products referred to in the content. |
© 2023 by the authors. Licensee MDPI, Basel, Switzerland. This article is an open access article distributed under the terms and conditions of the Creative Commons Attribution (CC BY) license (https://creativecommons.org/licenses/by/4.0/).
Share and Cite
Tian, J.; Paterson, T.E.; Zhang, J.; Li, Y.; Ouyang, H.; Asencio, I.O.; Hatton, P.V.; Zhao, Y.; Li, Z. Enhanced Antibacterial Ability of Electrospun PCL Scaffolds Incorporating ZnO Nanowires. Int. J. Mol. Sci. 2023, 24, 14420. https://doi.org/10.3390/ijms241914420
Tian J, Paterson TE, Zhang J, Li Y, Ouyang H, Asencio IO, Hatton PV, Zhao Y, Li Z. Enhanced Antibacterial Ability of Electrospun PCL Scaffolds Incorporating ZnO Nanowires. International Journal of Molecular Sciences. 2023; 24(19):14420. https://doi.org/10.3390/ijms241914420
Chicago/Turabian StyleTian, Jingjing, Thomas E. Paterson, Jingjia Zhang, Yingxing Li, Han Ouyang, Ilida Ortega Asencio, Paul V. Hatton, Yu Zhao, and Zhou Li. 2023. "Enhanced Antibacterial Ability of Electrospun PCL Scaffolds Incorporating ZnO Nanowires" International Journal of Molecular Sciences 24, no. 19: 14420. https://doi.org/10.3390/ijms241914420
APA StyleTian, J., Paterson, T. E., Zhang, J., Li, Y., Ouyang, H., Asencio, I. O., Hatton, P. V., Zhao, Y., & Li, Z. (2023). Enhanced Antibacterial Ability of Electrospun PCL Scaffolds Incorporating ZnO Nanowires. International Journal of Molecular Sciences, 24(19), 14420. https://doi.org/10.3390/ijms241914420

